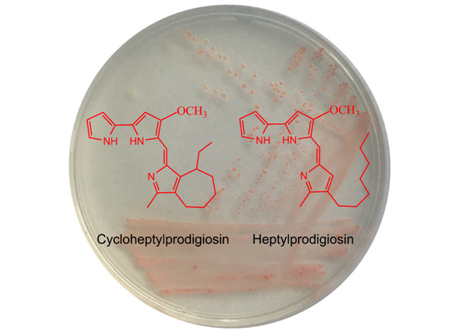

研究结果以“Spartinivicinusruber gen. nov., sp. nov., a novel marine gammaproteobacterium producing heptylprodigiosin and cycloheptylprodigiosin as major red pigments”为题目,发表在国际学术期刊《Frontiers in Microbiology》(SCI期刊2区,Journal IF=4.2,5-Year IF=4.9),文章链接https://www.frontiersin.org/articles/10.3389/fmicb.2020.02056/full。
1. 红色米草根际细菌S2-4-1H的菌落形态及其产生的两种灵菌红素的化学结构
灵菌红素是微生物产生的一类红色素,其结构中具有三个吡咯环。灵菌红素在抗菌、抗肿瘤、免疫抑制、抗病毒、纺织染料等方面具有重要生物活性及应用前景。灵菌红素的历史可以追溯到亚历山大大帝(Alexander the Great)举办的一种仪式——找寻“血红的面包”。目前已经知道,这种“血红的面包”是由粘质沙雷氏菌(Serratia marcescens)产生的一种红色色素物质引起的。随后这种红色物质被命名为灵菌红素(prodigiosin)。直至1960年,通过化学合成的方法首次确定了灵菌红素(prodigiosin)的化学结构,为2-甲基-3-戊基-6-甲氧基吡咯。2006年,一种合成的灵菌红素类衍生物obatoclax GX15-070,作为抗癌治疗药物进入临床II期。
本研究从泉州湾近岸互花米草生长区沉积物分离到一株新的红色海洋细菌菌株S2-4-1HT(= MCCC 1K03745T = KCTC 72148T),经过多相分类及保守基因串联的系统发育分析,鉴定该菌为一个新属、新种,命名为红色米草根际细菌(Spartinivicinusruber)。经过菌株培养、化合物提取、分离、质谱及核磁谱解析结构,同时分离出两种红色的化合物,分别鉴定为庚基灵菌红素(heptylprodigiosin,分子式C22H29N3O)与环庚基灵菌红素(cycloheptylprodigiosin,分子式C22H27N3O)(图1)。通过抑菌实验表明,这两种灵菌红素均具有较好的抑菌效果,并且环庚基灵菌红素具有更好的抑菌效果。

2. 红色米草根际细菌S2-4-1H的基因组及基因注释
应用PacBio RSII三代测序技术并结合Illumina Hiseq二代测序技术对该菌进行了全基因组测序,基因组大小6,687,090 bp,包括一个染色体及三个质粒(图2)。通过基因注释分析发现这两种红色素的合成是由一个包含29个基因形成的基因簇完成的,其中的一个基因(图3.红色箭头)可能负责由直链结构(庚基灵菌红素素)催化形成环形结构(环庚基灵菌红素)。

3. 灵菌红素合成基因簇
本研究为灵菌红素类的生物技术应用提供了新的菌种资源及化合物,为后续灵菌红素在生物医药、纺织染料、食品等方面的应用提供基础。
英国威廉希尔公司官网海洋与食品学院、福建省藻类活性物质制备与功能开发重点实验室为第一单位,黄兆斌博士与董乐教授为共同第一及通讯作者,自然资源部第三海洋研究所赖其良博士参与菌种鉴定工作、华侨大学医学院刘接卿博士参与化合物的结构解析。本研究得到校人事处“引进人才黄兆斌博士科研启动费” (H19005) 及福建省科技厅引导项目 (2016N0028)资助。
(黄兆斌 供稿)
